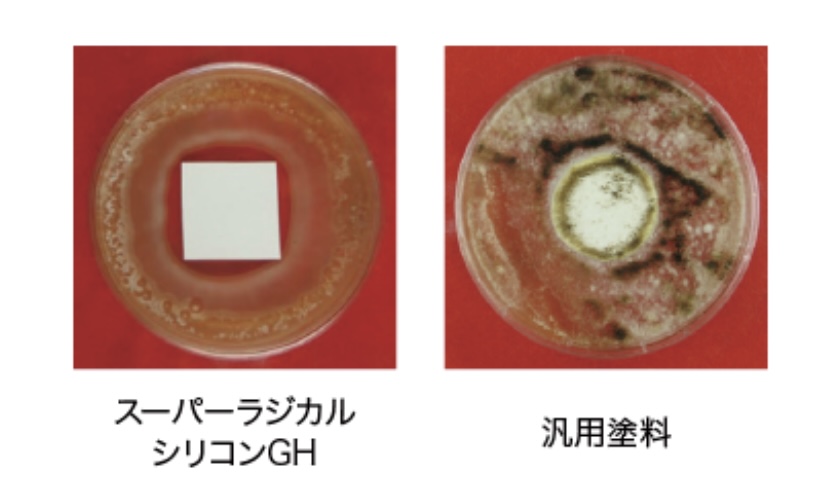
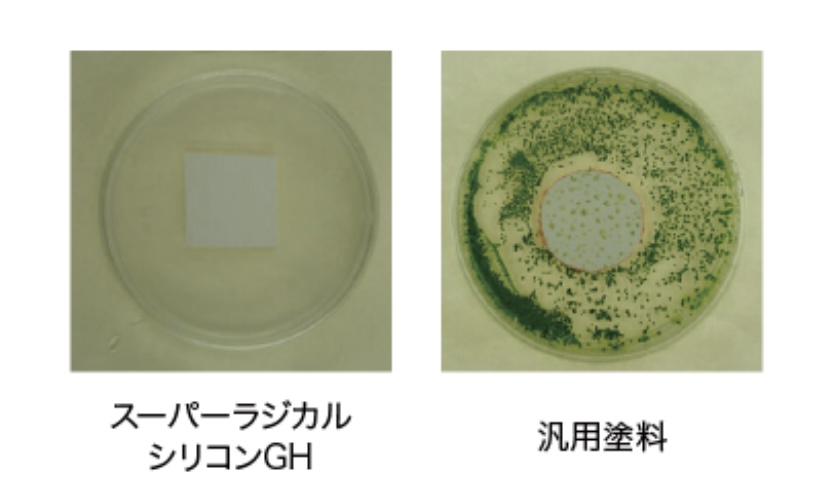

スタッフブログ
【外壁用塗料】スーパーラジカルシリコンGH
2026.03.23
スタッフブログ
大村市で外壁塗装・屋根塗装を専門に行っている【プロタイムズ大村店】です。
当ブログでは、外壁の劣化症状の見分け方や塗料の選び方、
工事の適切なタイミングなど、住まいを長持ちさせるための役立つ情報を発信しています。
これから外壁塗装・屋根塗装・内装・雨漏れ、その他小工事を検討されている方は、
ぜひ参考にしてください!
【スーパーラジカルシリコンGH】

劣化要因ラジカルを抑え家を保護する
特徴・・『耐候性』
劣化要因ラジカルの発生を抑え、封じ込める2つの技術
ラジカルとは、紫外線の影響を受けて発生する劣化因子です。
従来塗料に使用される顔料の主成分「酸化チタン」は、紫外線の
影響を受けて大量のラジカルを発生させてしまうことが課題でした。
スーパーラジカルシリコンGHでは2つの技術により、ラジカルの発生を抑え、
発生したラジカルも封じ込め、長期間建物を保護します。
〈技術1〉ラジカル制御型白色顔料
スーパーラジカルシリコンGHは、酸化チタンではなく
「ラジカル制御型白色顔料」を採用。ラジカルが発生しにくく、
またラジカルが発生した場合にも、シールド層によって封じ込め、
塗面の劣化を防ぎます。

〈技術2〉HALS(光安定剤)
さらにスーパーラジカルシリコンGHは、発生したラジカルを捕捉する
「HALS(光安定剤)」を配合。HALSがラジカルを捕捉することで塗面の劣化を
防ぎます。
※HALS:Hindered Amine Light Stabilizer(光安定剤)

期待耐用年数12~14年
促進耐候性試験(キセノンランプ式)において、約12~14年
(期待耐用年数)経過後も光沢保持率80%保持。
※あくまで試験環境下における推測値であり、高耐候性を保証するもの
ではありません。
※実際に紫外線にさらされる環境や下地の状態、施工方法、気象条件など
によって耐候性は異なる場合があります。

特徴・・『低汚染性』
汚れが付着しにくく、美観を保持する「低汚染性」を実現
一般的なシリコン塗料に使用されているアクリルシリコン樹脂は、
表層が柔れかく、汚れが付着しやすいのが課題でした。
スーパーラジカルシリコンGHは、柔らかい層を強靭な層でコーティングした
二重構造アクリルシリコン樹脂を採用。塗面に汚れが付着しにくい、
「低汚染性」を実現しました。

特徴・・『防カビ・防藻性』
さらにカビや藻の発生を防ぐ「防カビ・防藻性」を発揮!
「JIS Z 2911かび抵抗性試験方法」および「藻抵抗性試験(社内試験のよる)」に合格。
カビ・藻の発生を抑え、建物の美観を長く保ちます。
〈カビ/培養4週間後の様子〉
〈藻/培養4週間後の様子〉
大切なお住まい長く、美しく保つためには、
定期的な外壁・屋根塗装が欠かせません。
大村市で外壁塗装・屋根塗装など、ご検討中の方は、
ぜひ弊社へお気軽にご相談ください。
劣化状況を丁寧に診断し、最適な塗装プランをご提案いたします💡
【劣化診断・見積り・相談】無料🍀
株式会社ソエジマ【プロタイムズ大村店】
場所:〒856-0826 長崎県大村市水主町2-627-1
TEL:0120-066-116














